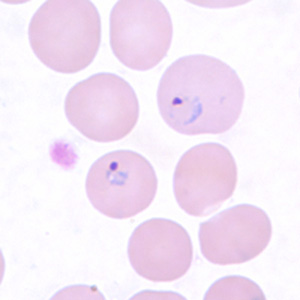

Malaria
[Plasmodium falciparum] [Plasmodium knowlesi] [Plasmodium malariae] [Plasmodium ovale] [Plasmodium vivax]
Causal Agent
Blood parasites of the genus Plasmodium. There are approximately 156 named species of Plasmodium which infect various species of vertebrates. Four species are considered true parasites of humans, as they utilize humans almost exclusively as a natural intermediate host: P. falciparum, P. vivax, P. ovale and P. malariae. However, there are periodic reports of simian malaria parasites being found in humans, most reports implicating P. knowlesi. At the time of this writing, it has not been determined if P. knowlesi is being naturally transmitted from human to human via the mosquito, without the natural intermediate host (macaque monkeys, genus Macaca). Therefore, P. knowlesi is still considered a zoonotic malaria.
Life Cycle

The malaria parasite life cycle involves two hosts. During a blood meal, a malaria-infected female Anopheles mosquito inoculates sporozoites into the human host  . Sporozoites infect liver cells
. Sporozoites infect liver cells  and mature into schizonts
and mature into schizonts  , which rupture and release merozoites
, which rupture and release merozoites  . (Of note, in P. vivax and P. ovale a dormant stage [hypnozoites] can persist in the liver and cause relapses by invading the bloodstream weeks, or even years later.) After this initial replication in the liver (exo-erythrocytic schizogony
. (Of note, in P. vivax and P. ovale a dormant stage [hypnozoites] can persist in the liver and cause relapses by invading the bloodstream weeks, or even years later.) After this initial replication in the liver (exo-erythrocytic schizogony  ), the parasites undergo asexual multiplication in the erythrocytes (erythrocytic schizogony
), the parasites undergo asexual multiplication in the erythrocytes (erythrocytic schizogony  ). Merozoites infect red blood cells
). Merozoites infect red blood cells  . The ring stage trophozoites mature into schizonts, which rupture releasing merozoites
. The ring stage trophozoites mature into schizonts, which rupture releasing merozoites  . Some parasites differentiate into sexual erythrocytic stages (gametocytes)
. Some parasites differentiate into sexual erythrocytic stages (gametocytes)  . Blood stage parasites are responsible for the clinical manifestations of the disease.
. Blood stage parasites are responsible for the clinical manifestations of the disease.
The gametocytes, male (microgametocytes) and female (macrogametocytes), are ingested by an Anopheles mosquito during a blood meal  . The parasites’ multiplication in the mosquito is known as the sporogonic cycle
. The parasites’ multiplication in the mosquito is known as the sporogonic cycle  . While in the mosquito’s stomach, the microgametes penetrate the macrogametes generating zygotes
. While in the mosquito’s stomach, the microgametes penetrate the macrogametes generating zygotes  . The zygotes in turn become motile and elongated (ookinetes)
. The zygotes in turn become motile and elongated (ookinetes)  which invade the midgut wall of the mosquito where they develop into oocysts
which invade the midgut wall of the mosquito where they develop into oocysts  . The oocysts grow, rupture, and release sporozoites
. The oocysts grow, rupture, and release sporozoites  , which make their way to the mosquito’s salivary glands. Inoculation of the sporozoites into a new human host perpetuates the malaria life cycle.
, which make their way to the mosquito’s salivary glands. Inoculation of the sporozoites into a new human host perpetuates the malaria life cycle.
Geographic Distribution
Malaria generally occurs in areas where environmental conditions allow parasite multiplication in the vector. Malaria today is usually restricted to tropical and subtropical areas and altitudes below 1,500 m., although in the past malaria was endemic in much of North America, Europe and even parts of northern Asia, and today is still present on the Korean peninsula. However, this present distribution could be affected by climatic changes and population movements. Plasmodium falciparum is the predominant species in the world. P. vivax and P. ovale are traditionally thought to occupy complementary niches, with P. ovale predominating in Sub-Saharan Africa and P. vivax in the other areas; but their geographical ranges do overlap. These two species are not always distinguishable on the basis of morphologic characteristics alone, and the use of molecular tools will help clarify their diagnosis and exact distribution. P. malariae has wide global distribution, being found in South America, Asia, and Africa, but it is less frequent than P. falciparum in terms of association with cases of infection. P. knowlesi is found in southeast Asia.
More on: Malaria Risk Information and Prophylaxis by Country
Clinical Presentation
The symptoms of uncomplicated malaria can be rather non-specific and the diagnosis can be missed if health providers are not alert to the possibility of this disease. Since untreated malaria can progress to severe forms that may be rapidly (<24 hours) fatal, malaria should always be considered in patients who have a history of exposure (mostly: past travel or residence in disease-endemic areas). The most frequent symptoms include fever and chills, which can be accompanied by headache, myalgias, arthralgias, weakness, vomiting, and diarrhea. Other clinical features include splenomegaly, anemia, thrombocytopenia, hypoglycemia, pulmonary or renal dysfunction, and neurologic changes. The clinical presentation can vary substantially depending on the infecting species, the level of parasitemia, and the immune status of the patient. Infections caused by P. falciparum are the most likely to progress to severe, potentially fatal forms with central nervous system involvement (cerebral malaria), acute renal failure, severe anemia, or acute respiratory distress syndrome. Other species can also have severe manifestations. Complications of P. vivax malaria include splenomegaly (with, rarely, splenic rupture), and those of P. malariae include nephrotic syndrome.
Ring-form trophozoites of P. falciparum in thick and a thin blood smear.











Ring-form trophozoites of P. falciparum in thin blood smears exhibiting Maurer’s clefts.






Developing and older trophozoites of P. falciparum in thick and a thin blood smear.






Gametocytes of P. falciparum in thick and a thin blood smear.









Schizonts of P. falciparum in a thin blood smear.



Ring-form trophozoites of P. knowlesi in a thin blood smear.






Older, developing trophozoites of P. knowlesi in a thin blood smear.


Gametocytes of P. knowlesi in thin blood smears.


Schizonts of P. knowlesi in a thin blood smear.





Ring-form trophozoites of P. malariae in thick and think blood smears.




Trophozoites of P. malariae in a thick blood smear.


Band-form trophozoites of P. malariae in a thin blood smear.





Basket-form trophozoites of P. malariae in a thin blood smear.



Gametocytes of P. malariae in thick and a thin blood smear.






Schizonts of P. malariae in thick and a thin blood smear.










Ring-form trophozoites of P. ovale in thick and a thin blood smear.





Trophozoites of P. ovale in thick and thin blood smears.







Gametocytes of P. ovale in thick and thin blood smears.








Schizonts of P. ovale in thick and thin blood smears.







Ring-form trophozoites of P. vivax in thick and thin blood smears.

Trophozoites of P. vivax in thick and thin blood smears.







Gametocytes of P. vivax in thick and thin blood smears.








Ookinetes of P. vivax in thick and thin blood smears.





Schizonts of P. vivax in thick and thin blood smears.









Diagnostic Findings
Microscopy
Microscopy (morphologic analysis) continues to be the “gold standard” for malaria diagnosis. Parasites may be visualized on both thick and thin blood smears stained with Giemsa, Wright, or Wright-Giemsa stains. Giemsa is the preferred stain, as it allows for detection of certain morphologic features (e.g. Schüffner’s dots, Maurer’s clefts, etc.) that may not be seen with the other two. Ideally, the thick smears are used to detect the presence of parasites while the thin smears are used for species-level identification. Quantification may be done on both thick and thin smears.
| Plasmodium species | Stages found in blood | Appearance of Erythrocyte (RBC) | Appearance of Parasite |
|---|---|---|---|
| P. falciparum | Ring | normal; multiple infection of RBC more common than in other species; Maurer’s clefts (under certain staining conditions) | delicate cytoplasm; 1 to 2 small chromatin dots; occasional appliqué (accolé) forms |
| Trophozoite | normal; rarely, Maurer’s clefts (under certain staining conditions) | seldom seen in peripheral blood; compact cytoplasm; dark pigment | |
| Schizont | normal; rarely, Maurer’s clefts (under certain staining conditions) | seldom seen in peripheral blood; mature = 8 to 24 small merozoites; dark pigment, clumped in one mass | |
| Gametocyte | distorted by parasite | crescent or sausage shape; chromatin in a single mass (macrogametocyte) or diffuse (microgametocyte); dark pigment mass | |
| P. vivax | Ring | normal to 1.25x, round; occasionally fine Schüffner’s dots; multiple infection of RBC not uncommon | large cytoplasm with occasional pseudopods; large chromatin dot |
| Trophozoite | enlarged 1.5 to 2x; may be distorted; fine Schüffner’s dots | large amoeboid cytoplasm; large chromatin; fine, yellowish-brown pigment | |
| Schizont | enlarged 1.5 to 2x; may be distorted; fine Schüffner’s dots |
large, may almost fill RBC; mature = 12 to 24 merozoites; yellowish-brown, coalesced pigment | |
| Gametocyte | enlarged 1.5 to 2x; may be distorted; fine Schüffner’s dots | round to oval; compact; may almost fill RBC; chromatin compact, eccentric (macrogametocyte) or diffuse (microgametocyte); scattered brown pigment | |
| P. ovale | Ring | normal to 1.25x, round to oval; occasionally Schüffner’s dots; occasionally fimbriated; multiple infection of RBC not uncommon | sturdy cytoplasm; large chromatin |
| Trophozoite | normal to 1.25x; round to oval; some fimbriated; Schüffner’s dots | compact with large chromatin; dark-brown pigment | |
| Schizont | normal to 1.25x, round to oval, some fimbriated, Schüffner’s dots | mature = 6 to 14 merozoites with large nuclei, clustered around mass of dark-brown pigment | |
| Gametocyte | normal to 1.25x; round to oval, some fimbriated; Schüffner’s dots | round to oval; compact; may almost fill RBC; chromatin compact, eccentric (macrogametocyte) or more diffuse (microgametocyte); scattered brown pigment | |
| P. malariae | Ring | normal to 0.75x | sturdy cytoplasm; large chromatin |
| Trophozoite | normal to 0.75x; rarely, Ziemann’s stippling (under certain staining conditions) | compact cytoplasm; large chromatin; occasional band forms; coarse, dark-brown pigment | |
| Schizont | normal to 0.75x; rarely, Ziemann’s stippling (under certain staining conditions) | mature = 6 to 12 merozoites with large nuclei, clustered around mass of coarse, dark-brown pigment; occasional rosettes | |
| Gametocyte | normal to 0.75x; rarely, Ziemann’s stippling (under certain staining conditions) | round to oval; compact; may almost fill RBC; chromatin compact, eccentric (macrogametocyte) or more diffuse (microgametocyte); scattered brown pigment | |
| P. knowlesi | Ring | normal to 0.75x; multiple infection not uncommon. | delicate cytoplasm; 1 to 2 prominent chromatin dots; occasional appliqué (accolé) forms |
| Trophozoite | normal to 0.75x; rarely, Sinton and Mulligan’s stippling (under certain staining conditions) | compact cytoplasm; large chromatin; occasional band forms; coarse, dark-brown pigment | |
| Schizont | normal to 0.75x; rarely, Sinton and Mulligan’s stippling (under certain staining conditions) | mature = up to 16 merozoites with large nuclei, clustered around mass of coarse, dark-brown pigment; occasional rosettes; mature merozoites appear segmented | |
| Gametocyte | normal to 0.75x; rarely, Sinton and Mulligan’s stippling (under certain staining conditions) | round to oval; compact; may almost fill RBC; chromatin compact, eccentric (macrogametocyte) or more diffuse (microgametocyte); scattered brown pigment |
Molecular Diagnosis
 Agarose gel (2%) analysis of a PCR diagnostic test for species-specific detection of Plasmodium DNA.
Agarose gel (2%) analysis of a PCR diagnostic test for species-specific detection of Plasmodium DNA.
Morphologic characteristics of malaria parasites can determine a parasite species, however, microscopists may occasionally fail to differentiate between species in cases where morphologic characteristics overlap (especially Plasmodium vivax and P. ovale), as well as in cases where parasite morphology has been altered by drug treatment or improper storage of the sample. In such cases, the Plasmodium species can be determined by using confirmatory molecular diagnostic tests. In addition, molecular tests such as PCR can detect parasites in specimens where the parasitemia may be below the detectable level of blood film examination. The methods currently used at CDC are described below.
Species-specific PCR diagnosis of malaria
Plasmodium genomic DNA is extracted from 200 µl whole blood using the QIAamp Blood Kit (Cat. No. 29106; Qiagen Inc., Chatsworth, CA.) or a similar product that can yield the comparable concentration of genomic DNA from the same volume of blood.
Detection and identification of Plasmodium to the species level is done with a real-time PCR assay as described by Rougemont et al 2004. This is a dual duplex assay that detects P. falciparum and P. vivax in one reaction, and P. malariae and P. ovale in a parallel reaction, using species-specific TaqMan probes. In cases where infection by more than one Plasmodium species is suspected, there is an option to use a conventional nested PCR assay (Snounou el al, 1993) that has an improved resolution of mixed infection compared to the real-time PCR assay.
Agarose gel (2%) analysis of a PCR diagnostic test for species-specific detection of Plasmodium DNA. PCR was performed using nested primers of Snounou et al.1
- Lane S: Molecular base pair standard (50-bp ladder). Black arrows show the size of standard bands.
- Lane 1: The red arrow shows the diagnostic band for P. vivax (size: 120 bp).
- Lane 2: The red arrow shows the diagnostic band for P. malariae (size: 144 bp).
- Lane 3: The red arrow shows the diagnostic band for P. falciparum (size: 205 bp).
- Lane 4: The red arrow shows the diagnostic band for P. ovale (size: 800 bp).
Reference:
Mathieu Rougemont, Madeleine Van Saanen, Roland Sahli, Hans Peter Hinrikson, Jacques Bille and Katia Jaton. Detection of Four Plasmodium Species in Blood from Humans by 18S rRNA Gene Subunit-Based and Species-Specific Real-Time PCR Assays. J. Clin. Microbiol. 2004, 42(12):5636.
Snounou G, Viriyakosol S, Zhu XP, et al. High sensitivity detection of human malaria parasites by the use of nested polymerase chain reaction. Mol Biochem Parasitol 1993;61:315-320.
Antibody Detection
 Agarose gel (2%) analysis of a PCR diagnostic test for species-specific detection of Plasmodium DNA.
Agarose gel (2%) analysis of a PCR diagnostic test for species-specific detection of Plasmodium DNA.
Positive IFA result with P. malariae schizont antigen.
Malaria antibody detection for clinical diagnosis is performed using the indirect fluorescent antibody (IFA) test. The IFA procedure can be used as a diagnostic tool to determine if a patient has been infected with Plasmodium. Because of the time required for development of antibody and also the persistence of antibodies, serologic testing is not practical for routine diagnosis of acute malaria. However, antibody detection may be useful for:
- screening blood donors involved in cases of transfusion-induced malaria when the donor’s parasitemia may be below the detectable level of blood film examination
- testing a patient who has been recently treated for malaria but in whom the diagnosis is questioned
Species-specific testing is available for the four human species: P. falciparum, P. vivax, P. malariae, and P. ovale. Cross reactions often occur between Plasmodium species and Babesia species. Blood stage Plasmodium species schizonts (meronts) are used as antigen. The patient’s serum is exposed to the organisms; homologous antibody, if present, attaches to the antigen, forming an antigen-antibody (Ag-Ab) complex. Fluorescein-labeled antihuman antibody is then added, which attaches to the patient’s malaria-specific antibodies. When examined with a fluorescence microscope, a positive reaction is when the parasites fluoresce an apple green color.
Reference:
Sulzer AJ, and Wilson M. The fluorescent antibody test for malaria. Crit Rev Clin Lab Sci 1971;2:601-609.
Antigen Detection
In addition to microscopy and molecular methods, there are methods for detecting malaria parasites on the basis of antigens or enzymatic activities associated with the parasites. These methods are often packaged as individual test kits called rapid diagnostic tests or RDTs.
These methods include, among others:
- detection of an antigen (histidine rich protein-2, HRP-2) associated with malaria parasites (P. falciparum)
- detection of a Plasmodium specific aldolase
- detection of a Plasmodium associated lactate dehydrogenase (pLDH) either through its enzymatic activity or by immunoassay
There is currently only one RDT licensed for use in the United States. For additional information visit https://www.cdc.gov/malaria/hcp/diagnosis-testing/malaria-diagnostic-tests.html
Additional Guidance
Patients suspected of having an orthoebolavirus or orthomarburgvirus after travel to an area experiencing an Ebola or Marburg outbreak should be evaluated urgently for malaria infection as the symptoms of malaria infection are very similar to those of Ebola and Marburg. CDC provides guidance for malaria diagnosis in patients with suspected orthoebolavirus or orthomarburgvirus infection in the United States.
Bench Aids
Treatment Information
Information about treatment of malaria in the United States is available at https://www.cdc.gov/malaria/treatment/index.html.
Malaria is transmitted to humans by female mosquitoes of the genus Anopheles. Female mosquitoes take blood meals for egg production, and these blood meals are the link between the human and the mosquito hosts in the parasite life cycle. The successful development of the malaria parasite in the mosquito (from the “gametocyte” stage to the “sporozoite” stage) depends on several factors. The most important is ambient temperature and humidity (higher temperatures accelerate the parasite growth in the mosquito) and whether the Anophelessurvives long enough to allow the parasite to complete its cycle in the mosquito host (“sporogonic” or “extrinsic” cycle, duration 9 to 18 days). In contrast to the human host, the mosquito host does not suffer noticeably from the presence of the parasites.

Sequential images of the mosquito taking its blood meal
General Information
There are approximately 3,500 species of mosquitoes grouped into 41 genera. Human malaria is transmitted only by females of the genus Anopheles. Of the approximately 430 Anopheles species, only 30-40 transmit malaria (i.e., are “vectors”) in nature. The rest either bite humans infrequently or cannot sustain development of malaria parasites.
Geographic Distribution
Anophelines are found worldwide except Antarctica. Malaria is transmitted by different Anopheles species in different geographic regions. Within geographic regions, different environments support a different species.
Anophelines that can transmit malaria are found not only in malaria-endemic areas, but also in areas where malaria has been eliminated. These areas are thus at risk of re-introduction of the disease.
Life Stages
Like all mosquitoes, anopheles mosquitoes go through four stages in their life cycle: egg, larva, pupa, and adult. The first three stages are aquatic and last 7-14 days, depending on the species and the ambient temperature. The biting female Anopheles mosquito may carry malaria. Male mosquitoes do not bite so cannot transmit malaria or other diseases. The adult females are generally short-lived, with only a small proportion living long enough (more than 10 days in tropical regions) to transmit malaria.
Eggs
Adult females lay 50-200 eggs per oviposition. Eggs are laid singly directly on water and are unique in having floats on either side. Eggs are not resistant to drying and hatch within 2-3 days, although hatching may take up to 2-3 weeks in colder climates.
Larvae
Mosquito larvae have a well-developed head with mouth brushes used for feeding, a large thorax, and a segmented abdomen. They have no legs. In contrast to other mosquitoes, Anopheles larvae lack a respiratory siphon and for this reason position themselves so that their body is parallel to the surface of the water.

Bottom: Anopheles eggs are laid singly.
Larvae breathe through spiracles located on the 8th abdominal segment and therefore must come to the surface frequently.
The larvae spend most of their time feeding on algae, bacteria, and other microorganisms in the surface microlayer. They do so by rotating their head 180 degrees and feeding from below the microlayer. Larvae dive below the surface only when disturbed. Larvae swim either by jerky movements of the entire body or through propulsion with the mouth brushes.
Larvae develop through 4 stages, or instars, after which they metamorphose into pupae. At the end of each instar, the larvae molt, shedding their exoskeleton, or skin, to allow for further growth.




The larvae occur in a wide range of habitats but most species prefer clean, unpolluted water. Larvae of Anopheles mosquitoes have been found in fresh- or salt-water marshes, mangrove swamps, rice fields, grassy ditches, the edges of streams and rivers, and small, temporary rain pools. Many species prefer habitats with vegetation. Others prefer habitats that have none. Some breed in open, sun-lit pools while others are found only in shaded breeding sites in forests. A few species breed in tree holes or the leaf axils of some plants.
Pupae
The pupa is comma-shaped when viewed from the side. This is a transitional stage between larva and adult. The pupae does not feed, but undergoes radical metamorphosis. The head and thorax are merged into a cephalothorax with the abdomen curving around underneath. As with the larvae, pupae must come to the surface frequently to breathe, which they do through a pair of respiratory trumpets on the cephalothorax. After a few days as a pupa, the dorsal surface of the cephalothorax splits and the adult mosquito emerges onto the surface of the water.
The duration from egg to adult varies considerably among species and is strongly influenced by ambient temperature. Mosquitoes can develop from egg to adult in as little as 7 days but usually take 10-14 days in tropical conditions.


Adults
Like all mosquitoes, adult anopheles have slender bodies with 3 sections: head, thorax and abdomen.
The head is specialized for acquiring sensory information and for feeding. The head contains the eyes and a pair of long, many-segmented antennae. The antennae are important for detecting host odors as well as odors of aquatic larval habitats where females lay eggs. The head also has an elongate, forward-projecting proboscis used for feeding, and two sensory palps.
The thorax is specialized for locomotion. Three pairs of legs and a single pair of wings are attached to the thorax.
The abdomen is specialized for food digestion and egg development. This segmented body part expands considerably when a female takes a blood meal. The blood is digested over time serving as a source of protein for the production of eggs, which gradually fill the abdomen.
Anopheles mosquitoes can be distinguished from other mosquitoes by the palps, which are as long as the proboscis, and by the presence of discrete blocks of black and white scales on the wings. Adult Anopheles can also be identified by their typical resting position: males and females rest with their abdomens sticking up in the air rather than parallel to the surface on which they are resting.
Adult mosquitoes usually mate within a few days after emerging from the pupal stage. In some species, the males form large swarms, usually around dusk, and the females fly into the swarms to mate. The mating habitats of many species remain unknown.
Males live for about a week, feeding on nectar and other sources of sugar. Females will also feed on sugar sources for energy but usually require a blood meal for the development of eggs. After obtaining a full blood meal, the female will rest for a few days while the blood is digested and eggs are developed. This process depends on the temperature but usually takes 2-3 days in tropical conditions. Once the eggs are fully developed, the female lays them then seeks blood to sustain another batch of eggs.
The cycle repeats itself until the female dies. Females can survive up to a month (or longer in captivity) but most do not live longer than 1-2 weeks in nature. Their chances of survival depend on temperature and humidity, but also upon their ability to successfully obtain a blood meal while avoiding host defenses.

Factors Involved in Malaria Transmission and Malaria Control
Understanding the biology and behavior of Anopheles mosquitoes can aid in designing appropriate control strategies. Factors that affect a mosquito’s ability to transmit malaria include its innate susceptibility to Plasmodium, its host choice, and its longevity. Long-lived species that prefer human blood and support parasite development are the most dangerous. Factors that should be taken into consideration when designing a control program include the susceptibility of malaria mosquitoes to insecticides and the preferred feeding and resting location of adult mosquitoes.
More on: How to Reduce Malaria’s Impact
Preferred Sources for Blood Meals
One important behavioral factor is the degree to which an Anopheles species prefers to feed on humans (anthropophily) or animals such as cattle (zoophily). Anthrophilic Anopheles are more likely to transmit the malaria parasites from one person to another. Most Anopheles mosquitoes are not exclusively anthropophilic or zoophilic; many are opportunistic and feed upon whatever host is available. However, the primary malaria vectors in Africa, An. gambiae and An. funestus, are strongly anthropophilic and, consequently, are two of the most efficient malaria vectors in the world.
Life Span
Once ingested by a mosquito, malaria parasites must undergo development within the mosquito before they are infectious to humans. The time required for development in the mosquito (the extrinsic incubation period) takes 9 days or longer, depending on the parasite species and the temperature. If a mosquito does not survive longer than the extrinsic incubation period, then she will not be able to transmit any malaria parasites.
It is not possible to measure directly the life span of mosquitoes in nature, but many studies have indirectly measured longevity by examination of their reproductive status or via marking, releasing, and recapturing adult mosquitoes. The majority of mosquitoes do not live long enough to transmit malaria, but some may live as long as three weeks in nature. Though evidence suggests that mortality rate increases with age, most workers estimate longevity in terms of the probability that a mosquito will live one day. Usually these estimates range from a low of 0.7 to a high of 0.9. If survivorship is 90% daily, then a substantial proportion of the population would live longer than 2 weeks and would be capable of transmitting malaria. Any control measure that reduces the average lifespan of the mosquito population will reduce transmission potential. Insecticides thus need not kill the mosquitoes outright, but may be effective by limiting their lifespan.
Patterns of Feeding and Resting
Most Anopheles mosquitoes are crepuscular (active at dusk or dawn) or nocturnal (active at night). Some Anopheles mosquitoes feed indoors (endophagic) while others feed outdoors (exophagic). After blood feeding, some Anopheles mosquitoes prefer to rest indoors (endophilic) while others prefer to rest outdoors (exophilic). Biting by nocturnal, endophagic Anopheles mosquitoes can be markedly reduced through the use of insecticide-treated bed nets (ITNs) or through improved housing construction to prevent mosquito entry (e.g., window screens). Endophilic mosquitoes are readily controlled by indoor spraying of residual insecticides. In contrast, exophagic/exophilic vectors are best controlled through source reduction (destruction of larval habitats).
Insecticide Resistance
Insecticide-based control measures (e.g., indoor spraying with insecticides, ITNs) are the principal way to kill mosquitoes that bite indoors. However, after prolonged exposure to an insecticide over several generations, mosquitoes, like other insects, may develop resistance, a capacity to survive contact with an insecticide. Since mosquitoes can have many generations per year, high levels of resistance can arise very quickly. Resistance of mosquitoes to some insecticides has been documented within a few years after the insecticides were introduced. There are over 125 mosquito species with documented resistance to one or more insecticides. The development of resistance to insecticides used for indoor residual spraying was a major impediment during the Global Malaria Eradication Campaign. Judicious use of insecticides for mosquito control can limit the development and spread of resistance, particularly via rotation of different classes of insecticides used for control. Monitoring of resistance is essential to alert control programs to switch to more effective insecticides.
Susceptibility/Refractoriness
Some Anopheles species are poor vectors of malaria, as the parasites do not develop well (or at all) within them. There is also variation within species. In the laboratory, it has been possible to select for strains of An. gambiae that are refractory to infection by malaria parasites. These refractory strains have an immune response that encapsulates and kills the parasites after they have invaded the mosquito’s stomach wall. Scientists are studying the genetic mechanism for this response. It is hoped that some day, genetically modified mosquitoes that are refractory to malaria can replace wild mosquitoes, thereby limiting or eliminating malaria transmission.
Related Case Studies
DPDx is an educational resource designed for health professionals and laboratory scientists. For an overview including prevention, control, and treatment visit www.cdc.gov/parasites/.













